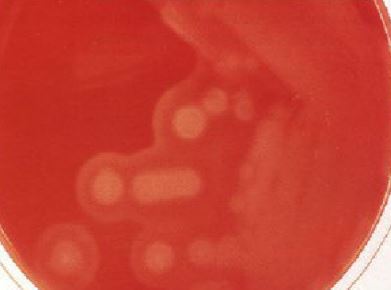
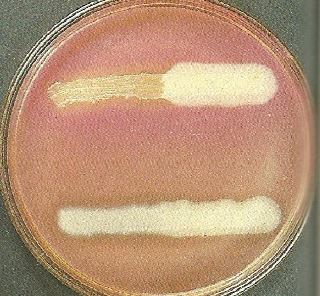
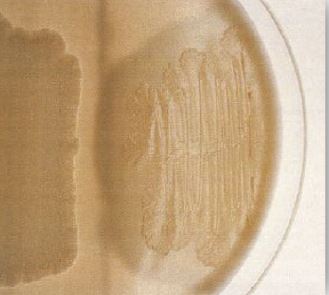

النبات

مواضيع عامة في علم النبات

الجذور - السيقان - الأوراق

النباتات الوعائية واللاوعائية

البذور (مغطاة البذور - عاريات البذور)

الطحالب

النباتات الطبية


الحيوان

مواضيع عامة في علم الحيوان

علم التشريح

التنوع الإحيائي

البايلوجيا الخلوية


الأحياء المجهرية

البكتيريا

الفطريات

الطفيليات

الفايروسات


علم الأمراض

الاورام

الامراض الوراثية

الامراض المناعية

الامراض المدارية

اضطرابات الدورة الدموية

مواضيع عامة في علم الامراض

الحشرات


التقانة الإحيائية

مواضيع عامة في التقانة الإحيائية


التقنية الحيوية المكروبية

التقنية الحيوية والميكروبات

الفعاليات الحيوية

وراثة الاحياء المجهرية

تصنيف الاحياء المجهرية

الاحياء المجهرية في الطبيعة

أيض الاجهاد

التقنية الحيوية والبيئة

التقنية الحيوية والطب

التقنية الحيوية والزراعة

التقنية الحيوية والصناعة

التقنية الحيوية والطاقة

البحار والطحالب الصغيرة

عزل البروتين

هندسة الجينات


التقنية الحياتية النانوية

مفاهيم التقنية الحيوية النانوية

التراكيب النانوية والمجاهر المستخدمة في رؤيتها

تصنيع وتخليق المواد النانوية

تطبيقات التقنية النانوية والحيوية النانوية

الرقائق والمتحسسات الحيوية

المصفوفات المجهرية وحاسوب الدنا

اللقاحات

البيئة والتلوث


علم الأجنة

اعضاء التكاثر وتشكل الاعراس

الاخصاب

التشطر

العصيبة وتشكل الجسيدات

تشكل اللواحق الجنينية

تكون المعيدة وظهور الطبقات الجنينية

مقدمة لعلم الاجنة


الأحياء الجزيئي

مواضيع عامة في الاحياء الجزيئي


علم وظائف الأعضاء


الغدد

مواضيع عامة في الغدد

الغدد الصم و هرموناتها

الجسم تحت السريري

الغدة النخامية

الغدة الكظرية

الغدة التناسلية

الغدة الدرقية والجار الدرقية

الغدة البنكرياسية

الغدة الصنوبرية

مواضيع عامة في علم وظائف الاعضاء

الخلية الحيوانية

الجهاز العصبي

أعضاء الحس

الجهاز العضلي

السوائل الجسمية

الجهاز الدوري والليمف

الجهاز التنفسي

الجهاز الهضمي

الجهاز البولي


المضادات الميكروبية

مواضيع عامة في المضادات الميكروبية

مضادات البكتيريا

مضادات الفطريات

مضادات الطفيليات

مضادات الفايروسات

علم الخلية

الوراثة

الأحياء العامة

المناعة

التحليلات المرضية

الكيمياء الحيوية

مواضيع متنوعة أخرى

الانزيمات
الجنس Clostridium perfringens
المؤلف:
عبد الرزاق سليمان التومي ، محمد محمد الامام ، عبد الباسط رمضان
المصدر:
اساسيات التشخيص البكتريولوجي المعملي والسريري
الجزء والصفحة:
14-7-2016
7158
Clostridium perfringens
يتواجد هذا النوع البكتيري بصورة كبيرة في التربة والقناة الهظمية للإنسان والحيوان وكذلك المياه، الخلايا البكتيرية تكون موجبة لصبغة جرام أما المزرعة البكتيرية القديمة فقد تظهر خلايا سالبة لهذه الصبغة وهي عبارة عن عصيات كبيرة بسمك 1 ميكرومتر وبطول 8-3 ميكرومتر وغير متحركة بخلاف بقية أنواع هذا الجنس البكتيري، كما أنها تفضل النمو في ظروف لا هوائية في درجة حرارة 37 درجة مئوية ويكون شكل المستعمرات البكتيرية محدب convex ، أملس . ومن النادر ملاحظة وجود الأبواغ عند فحص الأنسجة المصابة، بعض السلالات تكون حافظة داخل الأنسجة . يتم تصنيف النوع البكتيري C. perfringens بناءاً على المستضد السطحي surface antigen والذيفانات التي يفرزها ، حيث هناك 5 انواع من E – A ويسبب النوع A والنوع C الإصابات للإنسان أما بقية الأنواع فتصيب الحيوان . جميع هذه الانواع تفرز ذيفان من نوع a-toxin وهو من النوع المميت ، أما سلالات النوع C فتنتج ذيفان من النوع B-toxin بالإضافة لهذا الذيفان.

مستعمرات النوع البكتيري C. perfringens بصبغة جرام
الامراضية :
ــ النوع البكتيري C. perfringens النوع Al : وهو يسبب مرض الغر غرينا (تخر العضلات myonecrosis) والتهاب النسيج الخلوي اللاهوائي anaerobic cellulitis وإصابات حمى النفاس puerperal infection وتجرثم الدم. تحدث الإصابة بالغر غرينا في ظروف لا هوائية حيث تتضاعف الخلايا البكتيرية مفرزة عدة ذيفانات من بينها ذيفان من نوع a toxin مما يؤدي للتكسير السريع للمواد الكربوهيدراتية المتواجدة في النسيج فينتج غاز يحلل الانسجة السريع للمواد الكربوهيدراتية المتواجدة في النسيج فينتج غاز يحلل الأنسجة وخاص العضلات الأمر الذي يؤدي لتكون رائحة غير مقبولة (نتنة) كما ان تجرثم الدم septicaemia يؤدي إلى تحلل لكريات الدم intravascular haemolysis . ويعتبر الذيفان a toxin العامل الرئيسي لتحلل الأنسجة وتسمم الدم toxaemia ومن المعلوم أن الغر غرينا تحدث بعد تلوث الجروح وخاصة في الأنسجة التي لا يصلها الدم بصورة جيدة مع العلم بانه بإمكان النوع البكتيري C. novyi والنوع البكتيري C. septicum إحداث مثل هذه الإصابة، ويتم علاج هذه الإصابة بالتدخل الجراحي لإزالة النسيج المصاب مع تناول جرعة كبيرة من المضاد الحيوي penicillin عن طريق الوريد، كما أن العلاج الهوائي hyperbaric O2 أعطى نتيجة فعالة في بعض الحالات حيث يستنشق المريض غاز الأوكسجين النقي من خلال قناع في حجرة الضغط (ويضغط 3 atm = 303 kPa لعدة مرات ولفترات تصل إلى ساعتين).
ــ النوع البكتيري C. perfringens النوع A2 : يسبب هذا النوع تسمم الأغذية food poisoning عادة خلال 12-8 ساعة من تناول الغذاء الملوث، حيث يكون هذا النوع البكتيري أبواغ (تجرثم) داخل الأمعاء الدقيقة مفرزة ذيفان معوي غير مقاوم للحرارة heat labile enterotoxin يؤثر على نفاذية غشاء الأمعاء الدقيقة وأغلب هذه الإصابات تنجلي دون لعلاج أو تحاليل معملية.
ــ النوع البكتيري C. perfringens النوع C : يسبب هذا النوع التهاب الصائم jejunitis (الجزء الأوسك من الأمعاء الدقيقة) ويعرف بنخر القولون المعوي necrotizing enterocolitis ويسمى pigbel. وفي الغالب فإن الإصابة تكون ناتجة من إفراز B-toxin بعد تناول لحم الخنزير غير المطهي جيداً وهذا المرض شائع الانتشار في الصين وغينياً الجديدة وبنغلاديش وأجزاء من شرق أفريقيا ، وغالباً ما تكون الإصابة مميتة خاصة في الأطفال.
التشخيص المعملي:
تعتبر عينة الجروح والنسيج والتالف والإفرازات من أهم العينات التي تفيد في التشخيص المعملي للغرغرينا الغازية ، كما أن عينة البراز تفيد في تشخيص حالات التسمم الغذائي.
يمكن تنمية المزرعة البكتيرية في ظروف لا هوائية اختيارية أو قليلة التهوية micraerophilic وتعتبر درجة حرارة ما بين 45-37 درجة مئوية هي الدرجة المثلى.
ــ الوسط الغذائي blood agar : المستعمرات البكتيرية النامية تكون كبيرة الحجم وتظهر إحلالاً كاملاً لكريات الدم الحمراء B haemolysis (أغلب السلالات البكتيرية المسببة لتسمم الأغذية ليس لها القدرة على إحلال كريات الدم الحمراء) كما أن بعض السلالات تظهر منطقتين لإحلال كريات الدم الحمراء (double zone of haemolysis). .
مستعمرات النوع البكتيري C. perfringens على الوسط الغذائي Blood agar
ــ الوسط الغذائي Neomycin blood agar : وهو وسط غذائي انتقائي يستعمل لعزل النوع البكتيري C. perfingens من المتواضع التي يعتقد احتوائها على العديد من الكائنات الدقيقة الممرضة مثل الجروح. عند تحضين هذا الوسط الغذائي في ظروف لا هوائية فإن العصيات البكتيرية السالبة لصبغة جرام سيتم تثبيطها.
ــ الوسط الغذائي Robertson's cooked meat medium (RCMM) :
المستعمرات البكتيرية بتكسير السكريات الذي يلاحظ بتغير لون اللحم إلى الأحمر مع ظهور رائحة كريهة، وتكسير بعض البروتينات المتواجدة في هذا الوسط الغذائي ويلاحظ ذلك بإسوداد لون اللحم مع رائحة كريهة.
لتشخيص حالات التسمم الغذائي فإنه يتم تحضين هذا الوسط الغذائي في كأس بوضعه في الحمام المائي أو الماء المغلي لمدة 90 دقيقة وذلك للقضاء على البكتريا المعوية غير المكونة للأبواغ، ثم بعد تحضين الوسط الغذائي في درجة حرارة 37-35 درجة مئوية يتم إعادة الزرع على الوسط الغذائي blood agar لمدة 48-24 ساعة.
الاختبارات الكيموحيوية :
ــ اختيار الكشف على انزيم catalase و انزيم oxidase : سالب.
ــ كما يعتبر استعمال الوسط الغذائي lactose egg yolk medium من أهم الاختبارات الكيموحيوية التي تستعمل لتعريف هذا النوع البكتيري.
النوع البكتيري C. perfringens على الوسط الغذائي lactose egg yolk agar
حيث يتم الكشف على فعالية انزيم lecithinase C ويلاحظ تعتم opaity الوسط الغذائي نتيجة لتكسر مادة الليسيثين المتواجد في صفار البيض egg yolk وإحلال انزيم lipase حيث ستتكون طبقة دهنية على المستعمرات البكتيرية النامية من تكون تعتم الوسط الغذائي حول هذه المستعمرات البكتيرية من خلال اختبار يعرف بــ Nagler reaction ، وتخمير سكر اللاكتوز يلاحظ بإجمرار الوسط الغذائي وإحمرار المستعمرات البكتيرية بمجرد تعرضها للهواء أما فاعلية انزيم proteinase فيلاحظ بتكون طبقة شفافة حول المستعمرات النامية نتيجة تكسر الكازين casein المتواجد في الحليب وبذلك فإن تفاعلات النوع البكتيري C. perfringens على الوسط الغذائي egg yolk medium كالتالي:
ــ إنتاج إنزيم lecithinase C (a toxin) .
ــ تخمير سكر اللاكتوز.
ــ عدم تكسير الدهون .
ــ عدم فاعلية إنزيم proteinase.
مستعمرات النوع البكتيري C. perfringens على الوسط الغذائي Egg yolk agar توضح إنتاج إنزيم lecithinase (الجانب الأيمن) وتكون إنزيم lipase على الجانب الأيسر.
 الاكثر قراءة في البكتيريا
الاكثر قراءة في البكتيريا
 اخر الاخبار
اخر الاخبار
اخبار العتبة العباسية المقدسة

الآخبار الصحية















 قسم الشؤون الفكرية يصدر كتاباً يوثق تاريخ السدانة في العتبة العباسية المقدسة
قسم الشؤون الفكرية يصدر كتاباً يوثق تاريخ السدانة في العتبة العباسية المقدسة "المهمة".. إصدار قصصي يوثّق القصص الفائزة في مسابقة فتوى الدفاع المقدسة للقصة القصيرة
"المهمة".. إصدار قصصي يوثّق القصص الفائزة في مسابقة فتوى الدفاع المقدسة للقصة القصيرة (نوافذ).. إصدار أدبي يوثق القصص الفائزة في مسابقة الإمام العسكري (عليه السلام)
(نوافذ).. إصدار أدبي يوثق القصص الفائزة في مسابقة الإمام العسكري (عليه السلام)


















